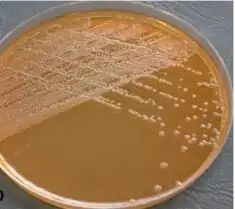

Elizabethkingia meningoseptica
| Elizabethkingia meningoseptica | |
|---|---|
 | |
| Wet raised colonies with clear margin and characteristic smell after culturing on blood agar, bacteria plated in this way may not show yellow color. Vancomycin sensitivity (clearing around disk) and colistin resistance may lead to mistaking this organism as Gram-positive. | |
| Scientific classification | |
| Domain: | Bacteria |
| Phylum: | Bacteroidota |
| Class: | Flavobacteriia |
| Order: | Flavobacteriales |
| Family: | Weeksellaceae |
| Genus: | Elizabethkingia |
| Species: | E. meningoseptica |
| Binomial name | |
| Elizabethkingia meningoseptica (King, 1959) Kim et al., 2005 | |
| Synonyms | |
| |
Elizabethkingia meningoseptica is a Gram-negative, rod-shaped bacterium widely distributed in nature (e.g. fresh water, salt water, or soil). It may be normally present in fish and frogs; it may be isolated from chronic infectious states, as in the sputum of cystic fibrosis patients. In 1959, American bacteriologist Elizabeth O. King (who isolated Kingella kingae in 1960) was studying unclassified bacteria associated with pediatric meningitis at the Centers for Disease Control and Prevention in Atlanta, when she isolated an organism (CDC group IIa) that she named Flavobacterium meningosepticum (Flavobacterium means "the yellow bacillus" in Latin; meningosepticum likewise means "associated with meningitis and sepsis").[1] In 1994, it was reclassified in the genus Chryseobacterium and renamed Chryseobacterium meningosepticum[2](chryseos = "golden" in Greek, so Chryseobacterium means a golden/yellow rod similar to Flavobacterium). In 2005, a 16S rRNA phylogenetic tree of Chryseobacteria showed that C. meningosepticum along with C. miricola (which was reported to have been isolated from Russian space station Mir in 2001 and placed in the genus Chryseobacterium in 2003[3]) were close to each other but outside the tree of the rest of the Chryseobacteria and were then placed in a new genus Elizabethkingia named after the original discoverer of F. meningosepticum.[4]
Microbiology
Under a microscope, E. meningoseptica appears as slender, slightly curved rods which are nonmotile and are negative by Gram stain. They do not form spores, and require oxygen to survive. E. meningoseptica is positive by the catalase test, the oxidase test, and the indole test. It is negative by the urease test. In general, it is negative by the nitrate reductase test, although some strains are positive.[5]
E. meningoseptica grows well on blood agar and chocolate agar. Colonies are very pale yellow and may not be easily evident at 24 hours. Strains growing better at 40 °C are mostly associated with invasive meningitis.[6] Often, a greyish discoloration is seen around the colonies on blood agar due to proteases and gelatinase. E. meningoseptica grows poorly on MacConkey agar and is considered a glucose oxidizer.[7] Most strains do not grow on colistin nalidixic acid agar because, although they are resistant to colistin, they are susceptible to quinolones such as nalidixic acid.
E. meningoseptica may show colistin-resistant and vancomycin-sensitive growth, which is paradoxic for a Gram-negative bacterium, but resembles Burkholderia cepacia, which is also a nonfermenter and does not grow well on MacConkey agar. These two can be distinguished by the indole test or the Pyr test, both of which should be clearly negative for B. cepacia and positive for E. meningoseptica. Automated bacterial identification system results should be observed with caution, especially when a patient with Gram-negative bacteremia does not improve with broad-spectrum antibiotic therapy, because several bacteria, including Aeromonas salmonicida (mistaken by ID32 GN[5]) and Sphingobacterium spp. (mistaken by Vitek 2[8]), may be confused with this bacterium, especially the atypical ones. However, unlike many other Aeromonas species such as A. hydrophila and A. punctata, A. salmonicida is indole negative, which can help in distinguishing it in doubtful cases. An automated but so far relatively reliable Rapid NF plus system and API Zym systems use an array of biochemical tests for better identification of nonfermenters and other bacteria and can specifically identify E. meningoseptica.
At the 2006 meeting of the International Committee on Systematics of Prokaryotes, the organization's subcommittee on the taxonomy of Flavobacterium and Cytophaga-like bacteria named J.-F. Bernardet and B. Bruun as two key authorities on this bacterium.[9]
Infection
E. meningoseptica predominantly causes outbreaks of meningitis in premature newborns and infants in neonatal intensive care units of underdeveloped countries.
Some of the outbreaks have been linked to sources such as contaminated lipid stock bottles, contaminated venous catheter lines and nutritional solution, and tap water. The bacterium is also a rare cause of nosocomial pneumonia, endocarditis, postoperative bacteremia, and meningitis in immunocompromised adults. Only recently has it also been found to cause soft-tissue infection and sepsis in the immunocompetent[8] and in a case of a fatal necrotizing fasciitis in a diabetic patient.[10]
Some 48 cases of Elizabethkingia infection resulting in 17 fatalities were reported in Wisconsin over a 5-month period beginning in November 2015.[11]
Antimicrobial susceptibility
This bacterium is usually multiresistant to antibiotics typically prescribed for treating Gram-negative bacterial infections, including extended-spectrum beta-lactam agents (due to production by most strains of two betalactamases: one ESBL and one class B carbapenem-hydrolyzing metallolactamase), aminoglycosides, tetracycline, and chloramphenicol. Though vancomycin has been used in the past, its high Minimum inhibitory concentration (16 µg/ml) has led to a search for alternatives, especially for meningitis. Presently, ciprofloxacin, minocycline, trimethoprim-sulfamethoxazole, rifampin, and novobiocin are considered good alternatives. Most of these are classic drugs for Gram-positive bacteria and not routinely tested on Gram-negative bacteria.[12]
Predictors of poor outcome
Hypoalbuminemia, increased pulse rate at the onset of infection, and central venous line infection were associated with a poor outcome.[13]
Presence in plants
Two species of Elizabethkingia have recently been found to be abundant on the leaf and root surfaces of the tropical tree Gnetum gnemon in Malaysia.[14] Their role in the biology of the plant is unknown. Several other species of tropical trees studied did not have Elizabethkingia present on their leaves or roots, suggesting a host-specific relationship with Gnetum.
See also
References
- ↑ E. O. King (1959). "Studies on a group of previously unclassified bacteria associated with meningitis in infants". American Journal of Clinical Pathology. 31 (3): 241–247. doi:10.1093/ajcp/31.3.241. PMID 13637033.
- ↑ P. Vandamme; J. F. Bernardet; P. Segers; K. Kersters; B. Holmes (1994). "New perspectives in the classification of the flavobacteria: description of Chryseobacterium gen. nov., Bergeyella gen. nov., and Empedobacter nom. rev". International Journal of Systematic Bacteriology. 44 (4): 827–831. doi:10.1099/00207713-44-4-827.
- ↑ Ying Li; Yoshiaki Kawamura; Nagatoshi Fujiwara; Takashi Naka; Hongsheng Liu; Xinxiang Huang; Kazuo Kobayashi; Takayuki Ezaki (2003). "Chryseobacterium miricola sp. nov., a novel species isolated from condensation water of space station Mir". Systematic and Applied Microbiology. 26 (4): 523–528. doi:10.1078/072320203770865828. PMID 14666980.
- ↑ Kwang Kyu Kim; Myung Kyum Kim; Ju Hyoung Lim; Hye Yoon Park; Sung-Taik Lee (2005). "Transfer of Chryseobacterium meningosepticum and Chryseobacterium miricola to Elizabethkingia gen. nov. as Elizabethkingia meningoseptica comb. nov. and Elizabethkingia miricola comb. nov". International Journal of Systematic and Evolutionary Microbiology. 55 (3): 1287–1293. doi:10.1099/ijs.0.63541-0. PMID 15879269.
- 1 2 Cheng-Hsun Chiu; Michael Waddingdon; Wu-Shiun Hsieh; David Greenberg; Paul C. Schreckenberger; Amy M. Carnahan (2000). "Atypical Chryseobacterium meningosepticum and meningitis and sepsis in newborns and the immunocompromised, Taiwan". Emerging Infectious Diseases. 6 (5): 481–486. doi:10.3201/eid0605.000506. PMC 2627967. PMID 10998378.
- ↑ Jean-François Bernardet; Celia Hugo; Brita Bruun (2006). "The Genera Chryseobacterium and Elizabethkingia". The Prokaryotes. New York: Springer. pp. 638–676. doi:10.1007/0-387-30747-8_25. ISBN 978-0-387-25497-5.
- ↑ Koneman's Color Atlas and Textbook of Diagnostic Microbiology
- 1 2 Felipe Francisco Tuon; Luciana Campon; Gisels Duboc de Almeida; Ronaldo Cesar Gryschek (2007). "Chryseobacterium meningosepticum as a cause of cellulitis and sepsis in an immunocompetent patient". Journal of Medical Microbiology. 56 (8): 1116–1117. doi:10.1099/jmm.0.47111-0. PMID 17644722.
- ↑ Jean-François Bernardet (2006). "International Committee on Systematics of Prokaryotes. Subcommittee on the taxonomy of Flavobacterium and Cytophaga-like bacteria. Minutes of the meetings, 26 July 2005, San Francisco, CA, USA" (PDF). International Journal of Systematic and Evolutionary Microbiology. 56 (12): 2949–2951. doi:10.1099/ijs.0.64834-0.
{{cite journal}}: CS1 maint: url-status (link) - ↑ Ching-Chi Lee; Po-Lin Chen; Li-Rong Wang; Hsin-Chun Lee; Chia-Ming Chang; Nan-Yao Lee; Chi-Jung Wu; Hsin-I Shih; Wen-Chien Ko (2006). "Fatal case of community-acquired bacteremia and necrotizing fasciitis caused by Chryseobacterium meningosepticum: case report and review of the literature". Journal of Clinical Microbiology. 44 (3): 1181–1183. doi:10.1128/JCM.44.3.1181-1183.2006. PMC 1393108. PMID 16517926.
- ↑ Meyers, Scottie Lee (March 9, 2016). "A Crash Course In Elizabethkingia, The Rare Bacterial Infection Spreading Across Wisconsin". Wisconsin Public Radio. Archived from the original on April 14, 2023. Retrieved April 26, 2023.
- ↑ Pen-Yi Lin; Chishih Chu; Lin-Hui Su; Chung-Tsui Huang; Wen-Ya Chang; Cheng-Hsun Chiu (2004). "Clinical and microbiological analysis of bloodstream infections caused by Chryseobacterium meningosepticum in nonneonatal patients". Journal of Clinical Microbiology. 42 (7): 3353–3355. doi:10.1128/JCM.42.7.3353-3355.2004. PMC 446307. PMID 15243115.
- ↑ Po-Pin Hung; Yu-Hui Lin; Chin-Fu Lin; Meei-Fang Liu; Zhi-Yuan Shi (2008). "Chryseobacterium meningosepticum infection: antibiotic susceptibility and risk factors for mortality" (PDF). Journal of Microbiology, Immunology and Infection. 41: 137–144. Archived (PDF) from the original on 2008-12-01. Retrieved 2023-04-26.
- ↑ Oh MY; Kim M; Lee-Cruz L; Lai-Hoe A; Ainuddin N; Rahim RA; Shukor N; Adams JM (2012). "Distinctive bacterial communities in the rhizoplane of four tropical tree species". Microbial Ecology. 64 (4): 1018–1027. doi:10.1007/s00248-012-0082-2. PMID 22767122. S2CID 16040513.
External links
- Type strain of Elizabethkingia meningoseptica at BacDive - the Bacterial Diversity Metadatabase Archived 2016-06-10 at the Wayback Machine